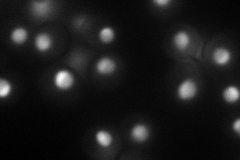
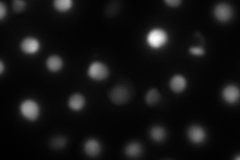
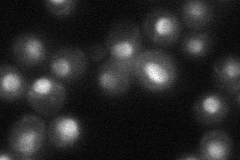
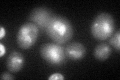
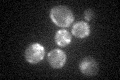

View description
RNAase III; involved in rDNA transcription and rRNA processing; also cleaves a stem-loop structure at the 3' end of U2 snRNA to ensure formation of the correct U2 3' end; involved in polyadenylation-independent transcription termination
Localization:
Intensity:
Fold change:
Significance:
-
C’ GFP library in SD

nucleus32.15 -
N' NOP1pr-GFP in SD
nucleolus79.0079 -
N' TEF2pr-mCherry in SD
nucleus,nucleolus104.231 -
N' NATIVEpr-GFP in SD
nucleus,nucleolus37.6484 -
N' TEF2pr-VC and Cyto-VN in SD

#N/A0 -
C’ GFP library in SD+DTT
nucleus24.280.75No -
C’ GFP library in SD+H2O2

nucleus29.720.92No -
C’ GFP library in Starvation Media
nucleus26.580.82No -
C’ GFP library on the background of Pup2-DaMP

nucleus -
C’ GFP library on the background of CCT mutant

nucleus31.60060.982734No
